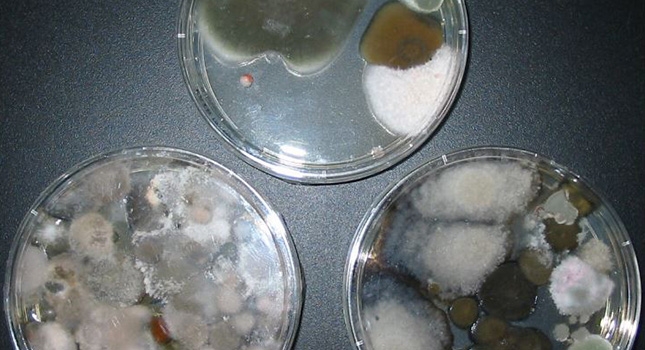

Atemwegserkrankungen verursacht durch zu feuchte oder schimmelige Wohnungen kosten Europa 82 Milliarden Euro pro Jahr. So das Ergebnis der neuen Studie des Fraunhofer-Instituts für Bauphysik IBP. Feuchtigkeit ist einer der größten Mängel von Gebäuden sowohl in Deutschland als auch in Europa, häufig verursacht durch unzureichende Baukonstruktionen und gegebenenfalls durch mangelhaftes Nutzerverhalten verstärkt. Die daraus entstehenden Schimmelschäden sind bei fachgerechter Sanierung sehr kostenintensiv. Prävention ist hier das A und O, weiß Dr. Gerhard Führer, Initiator und Veranstalter des Würzburger Schimmelpilz-Forums. Methoden der Prävention stehen daher im Fokus des 7. Fachforums.